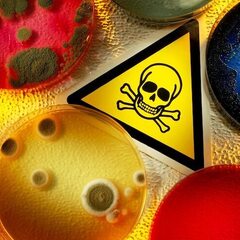

Подписаться
|
ОПРОС: Какую информацию об авторе комментария нужно ОСТАВИТЬ?
Проголосуйте, чтобы увидеть результаты:
242 комментария
|
||||
|
Роскачество обнаружило в полуфабрикатах известных марок антибиотики, сою и кишечную палочку
174 комментария
|
||||
|
Сегодня пятый день поисков пропавшего 11-летнего мальчика. Репортаж с места поиска
64 комментария
|
||||
|
Бесплатный аналог прививкам: в России – новый бум «ветряночных» вечеринок
44 комментария
|
||||
|
На войне атеистов нет! Российский боец пощадил солдата ВСУ, который встал на колени и начал молиться
220 комментариев
|
||||
30 комментариев
|
||||
188 комментариев
|
||||